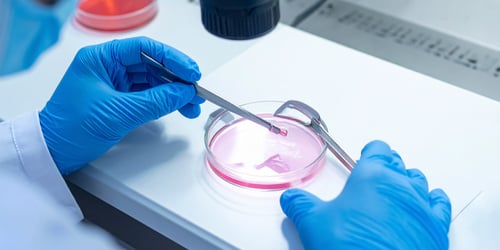
1-Nov-14-2025-02-48-57-8936-PM 1-Nov-14-2025-02-48-57-8936-PM

.png)
La solución integral para su centro de fertilidad
Digitalice todos los procesos clínicos y administrativos de su centro. Integre historias clínicas, material criopreservado, tratamientos y facturación en una plataforma adaptada específicamente a Fertilidad Asistida.
+200 centros médicos
+8500 usuarios activos
+2M de paciente registrados
Todo el flujo de fertilidad, digitalizado e integrado
Una plataforma completa diseñada específicamente para las necesidades de su centro de fertilidad.
Tratamientos de alta complejidad
Tratamientos de Baja Complejidad
Quirófanos Y Equipos Multidisciplinarios
Reportes RAFA / RED LARA
Comunicación con Pacientes
Envío digital de resultados y recordatorios personalizados por email o WhatsApp, mejorando la experiencia del paciente.
Vea Cómo Funciona
Descubra cómo nuestra plataforma transforma la gestión de centros de fertilidad
Transforme su centro con tecnología pensada para Fertilidad Asistida
♦ Automatización total: Elimine tareas manuales y optimice cada etapa del proceso clínico.
♦ Automatización total: Elimine tareas manuales y optimice cada etapa del proceso clínico.
♦ Mejor coordinación entre equipos médicos, embriólogos y administrativos.
%20(1).png?width=500&height=375&name=Sin%20t%C3%ADtulo%20(1200%20x%20900%20px)%20(1).png)
Mejore la comunicación y fidelización de sus pacientes
♦ Fichas personales vinculadas entre los pacientes intervinientes.
♦ Envío automático de recordatorios, indicaciones y resultados.
♦ Acceso digital seguro a informes e historial de tratamientos.
Toda la gestión clínica y administrativa en una misma plataforma
♦ Facturación adaptada a los tratamientos de Fertilidad Asistida.
♦ Informes RAFA generados automáticamente.
♦ Control de ingresos, gastos y rendimiento por profesional o tratamiento.

Clientes que nos eligen
Centros líderes en fertilidad de toda Latinoamérica
Agende una demo gratuita
Descubra cómo Omnia Salud puede transformar la gestión de su centro de fertilidad asistida
Preguntas Frecuentes
¿El software se adapta al flujo de trabajo de mi centro?
Sí, Omnia Salud se personaliza según la estructura y los procesos de cada clínica, integrando áreas médicas, administrativas y de laboratorio.
¿Puedo gestionar la criopreservación dentro del sistema?
Sí, la plataforma permite registrar, controlar y vincular el material criopreservado directamente con la historia clínica de cada paciente.
¿Incluye facturación electrónica y reportes RAFA?
Exactamente. Omnia genera automáticamente los reportes RAFA y contempla la facturación de tratamientos de Fertilidad según las normativas argentinas.
¿Los pacientes pueden recibir informes digitales?
Sí, puede enviar informes o resultados por correo o WhatsApp, integrados a la ficha clínica del paciente.
¿Qué tan rápido puedo implementarlo en mi centro?
El proceso de implementación es ágil y acompañado por nuestro equipo de soporte especializado en Fertilidad.